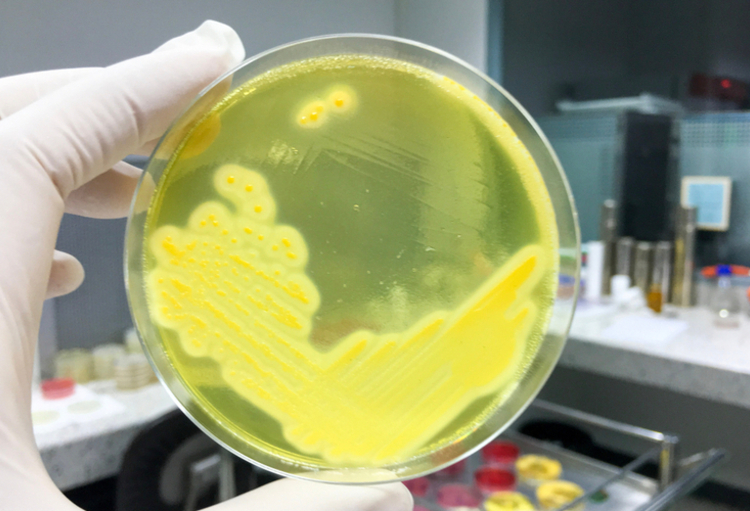
BDD: des perles, des thèses, des recherches

Un petit garçon de 9 ans est amené en consultation pour des abcès récurrents depuis quelques mois. L’anamnèse révèle que le père a eu le même problème avant lui. Une colonisation par Staphylococcus aureus est constatée chez les deux patients, le test PCR s’avérant positif pour la...
Vous souhaitez continuer à lire cet article ?
L'accès à la totalité de l'article est réservé aux professionnels de la santé.
Si vous êtes un professionnel de la santé vous devez vous connecter ou vous inscrire gratuitement sur notre site pour accéder à la totalité de notre contenu.
Si vous êtes journaliste ou si vous souhaitez nous informer écrivez-nous à redaction@rmnet.be.